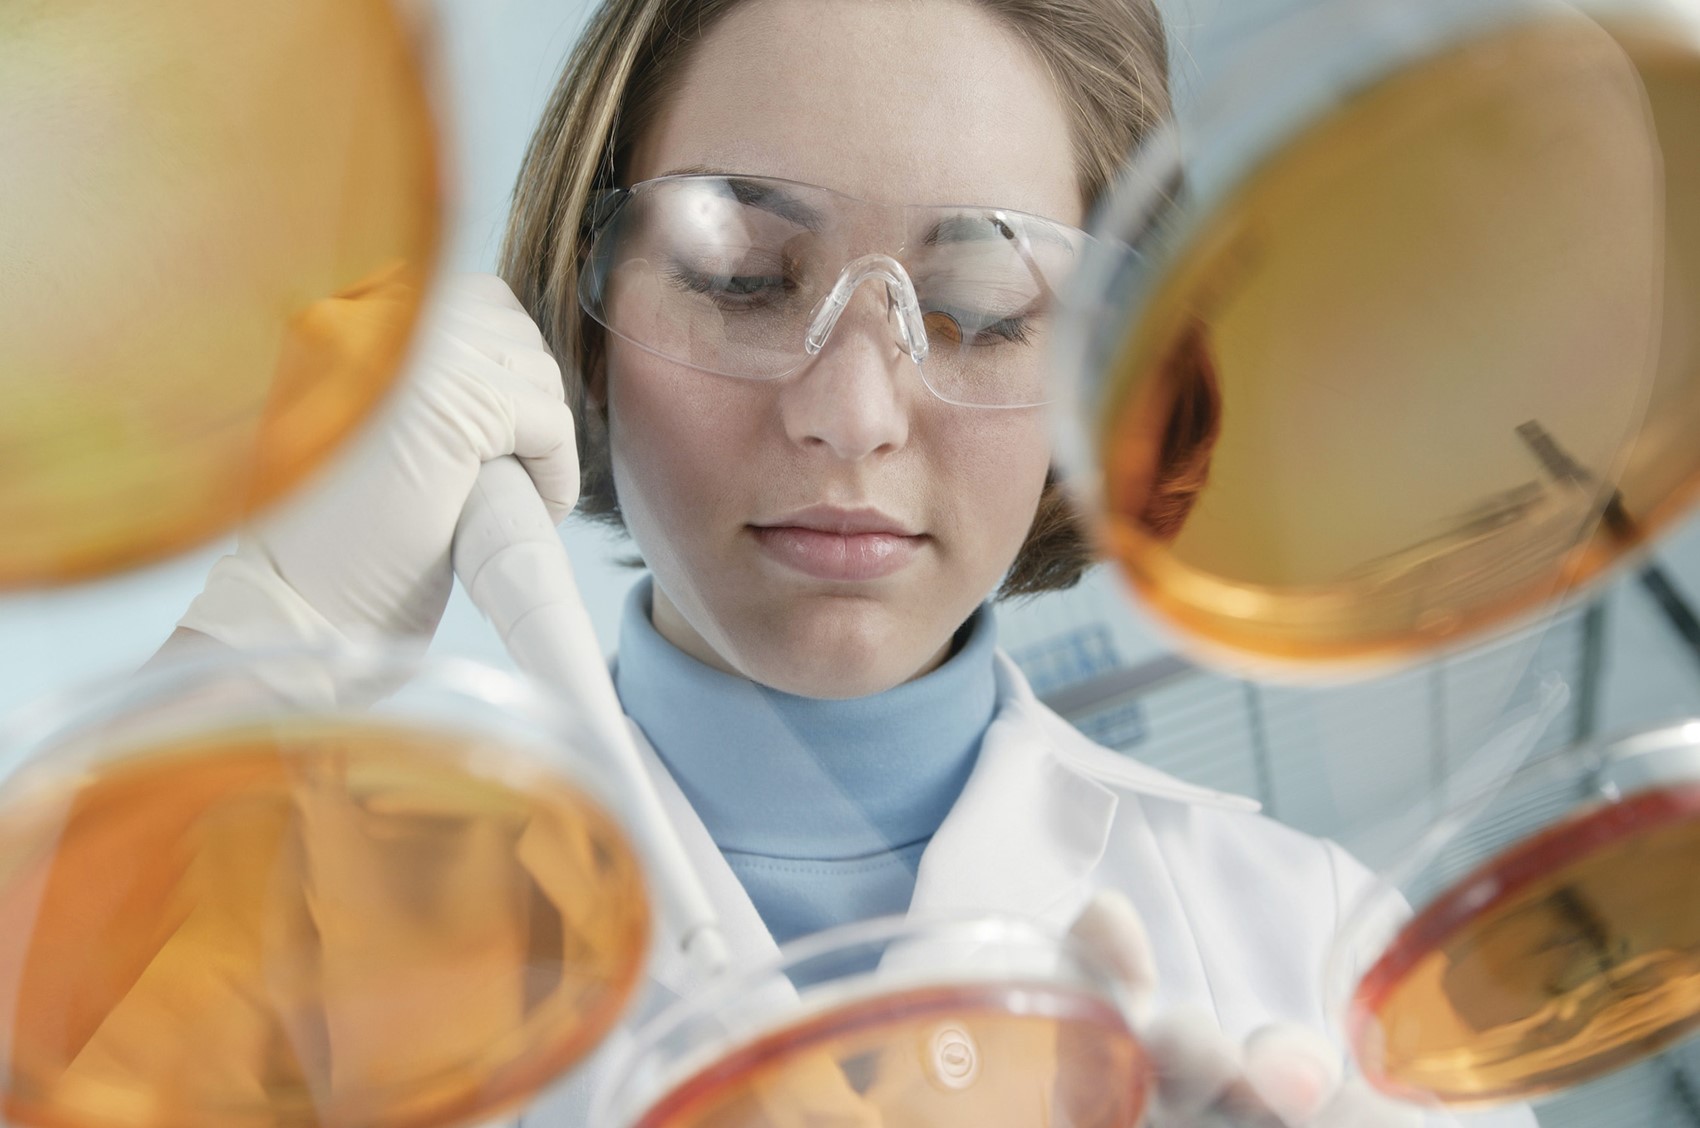

A recent study has introduced a new molecule that could help treat psoriasis. This molecule is special because it can be turned on and off using light. The team behind this discovery, led by Marc López-Cano and others, created this molecule to target a part of the body called the Adenosine A3 receptor.
The Adenosine A3 receptor is important in controlling inflammation, which is a big problem in conditions like psoriasis. When this receptor is activated, it can help reduce the inflammation that causes the painful symptoms of psoriasis.
What makes this molecule different is that it can be controlled by light. This means doctors could activate it only when needed, making treatments more precise and reducing the chance of unwanted side effects. Instead of taking medicine all the time, light could be used to turn the treatment on and off as needed.
Photopharmacology could improve treatments with fewer side effects, but it's not yet widely used. Two main challenges are designing safe drugs that work with light and creating compatible light sources for medical use.
More studies are needed, but this exciting discovery could lead to better treatments for psoriasis in the future, and may also be used to help other conditions related to inflammation.
The research was published in the Journal of the American Chemical Society in February 2025.
Reference:
López-Cano, M., Scortichini, M., Tosh, D. K., Salmaso, V., Ko, T., Salort, G., Filgaira, I., Soler, C., Trauner, D., Hernando, J., Jacobson, K. A., & Ciruela, F. (2025). Photoswitchable Diazocine Derivative for Adenosine A3 Receptor Activation in Psoriasis. Journal of the American Chemical Society, 147(3), 874–879. https://doi.org/10.1021/jacs.5b00001